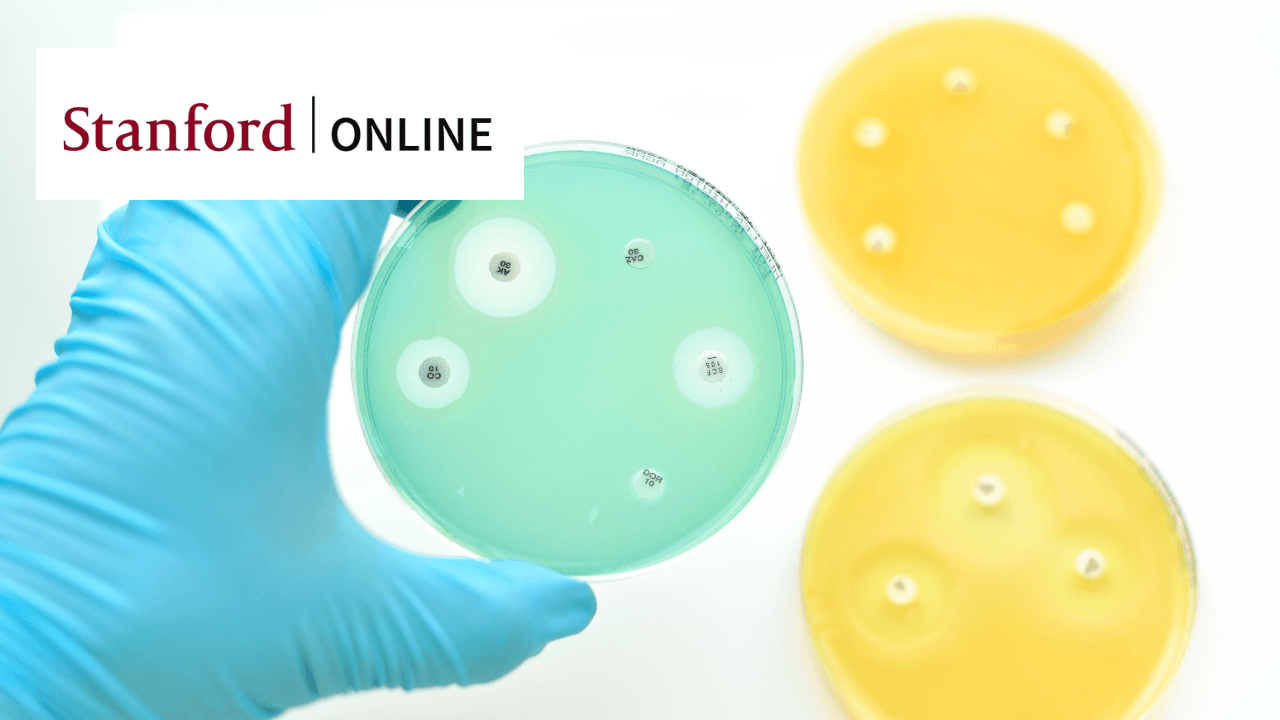
Antimicrobial Stewardship and Antibiotic Practices

Learn evidence-based principles of antibiotic use and develop antimicrobial stewardship programs to improve clinical outcomes and combat resistance.
Learn evidence-based principles of antibiotic use and develop antimicrobial stewardship programs to improve clinical outcomes and combat resistance.
This comprehensive course explores the critical aspects of appropriate antibiotic use and antimicrobial stewardship in clinical practice. Through video-based instruction, participants learn essential principles for managing common infections and developing effective stewardship programs. The curriculum addresses the significant challenge of antibiotic overuse, with approximately 50% of current prescriptions being inappropriate. Participants study evidence-based approaches to antibiotic prescription, practical case studies, and strategies for implementing stewardship programs. The course emphasizes both individual patient care and broader public health implications of antibiotic use, particularly focusing on preventing antibiotic resistance.
22,377 already enrolled
Instructors:
English
English
What you'll learn
Apply IDSA guidelines for treating common infections like sinusitis and bronchitis
Implement evidence-based practices for antimicrobial stewardship
Develop and lead effective antimicrobial stewardship programs
Optimize antibiotic therapy through standardized protocols
Skills you'll gain
This course includes:
PreRecorded video
Graded assignments, exams
Access on Mobile, Tablet, Desktop
Limited Access access
Shareable certificate
Closed caption
Get a Completion Certificate
Share your certificate with prospective employers and your professional network on LinkedIn.
Created by
Provided by

Top companies offer this course to their employees
Top companies provide this course to enhance their employees' skills, ensuring they excel in handling complex projects and drive organizational success.





Module Description
This advanced medical course focuses on optimizing antibiotic practices through antimicrobial stewardship. The curriculum combines theoretical knowledge with practical applications, featuring case studies and implementation strategies. Participants learn to apply evidence-based guidelines for treating common infections, develop stewardship programs, and understand the broader implications of antibiotic use on public health. The course emphasizes practical decision-making skills and provides continuing education credits for healthcare professionals.
Fee Structure
Instructors
Leading Antimicrobial Stewardship at Stanford Health Care
Emily Mui is an Infectious Disease Clinical Pharmacist at Stanford Health Care. She earned her PharmD from Northeastern University in Boston, MA, and completed her PGY1 Pharmacy Practice Residency at Brigham and Women’s Hospital, followed by PGY2 subspecialty training in Infectious Diseases. After practicing as a General Medicine Clinical Pharmacist, she transitioned to her current role in Antimicrobial Stewardship. Emily actively precepts Pharmacy residents during their Infectious Disease pharmacy practice rotation and guides Infectious Disease fellows through the Antimicrobial Stewardship rotation.

3 Courses
A Distinguished Leader in Infectious Disease Medicine and Antimicrobial Stewardship
Stan Deresinski serves as Clinical Professor of Medicine in Stanford's Division of Infectious Diseases and Geographic Medicine, where he directs the Antimicrobial Stewardship Program. After receiving his medical degree from the University of Illinois College of Medicine and completing his residency and fellowship training at Stanford, he built an impressive career spanning clinical practice, research, and education. His three decades of private practice included roles as Hospital Epidemiologist and Medical Staff President at Sequoia Hospital, while also serving as Associate Chief of Infectious Diseases and Director of the AIDS Program at Santa Clara Valley Medical Center. In 1987, he founded the AIDS Community Research Consortium, serving as its Medical Director for nearly two decades. His expertise spans antimicrobial resistance, optimal antimicrobial use, fungal infections, and infections in immunocompromised hosts. Currently chairing Stanford's Pharmacy and Therapeutics Committee and Specialty Drugs Subcommittee, he has published over 100 peer-reviewed papers and serves as Section Editor of Clinical Infectious Diseases. His contributions have earned him numerous honors, including the IDSA Watanakunakorn Clinician of the Year Award, while his leadership extends to roles on the IDSA Board of Directors and Standards and Practice Guidelines Committee.
Testimonials
Testimonials and success stories are a testament to the quality of this program and its impact on your career and learning journey. Be the first to help others make an informed decision by sharing your review of the course.
Frequently asked questions
Below are some of the most commonly asked questions about this course. We aim to provide clear and concise answers to help you better understand the course content, structure, and any other relevant information. If you have any additional questions or if your question is not listed here, please don't hesitate to reach out to our support team for further assistance.